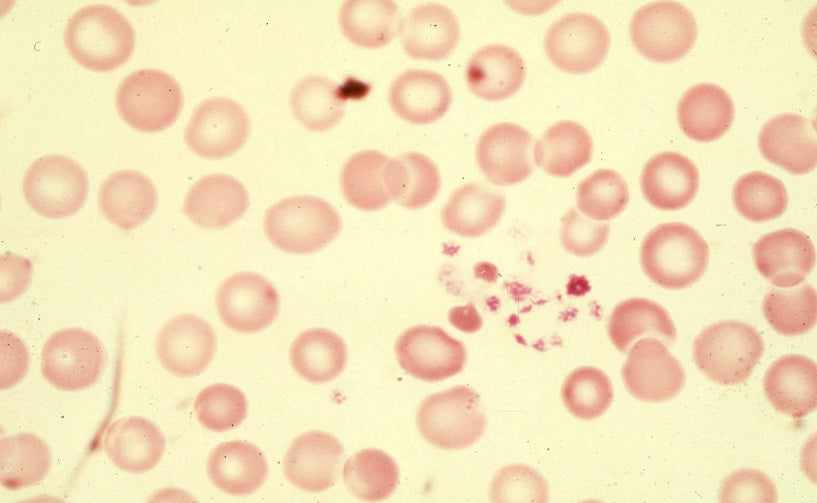

Platelets are the part of the blood clotting system which helps in tissue repair and stops bleeding by forming clots. Clot formation is known as haemostatis. Abnormally low blood platelet count is also known as thrombocytopenia, a serious blood disorder. In this case there is increased destruction and decreased production of platelets. Severely low platelet count may cause excessive blood loss as the platelets are an important part of haemoglobin that plays a vital role in blood coagulation process.
The normal platelet count is 150,000 and 450,000 per microliter. Exceptionally low platelet counts don’t have any prominent symptoms except bleeding or bruising from open cavities or internal bleeding. Purple spots on the skin, red or brown urine, vomiting blood, headache, abdominal pain, blurred vision are the other symptoms.
Low Platelet Count or Thrombocytopenia may occur due to:
1. Blood disorders like aplastic anaemia that affect bone marrow
2. Cancer such as leukaemia or lymphoma, which damages your bone marrow or due to chemotherapy
3. Platelet-lowering disease that run in your genetics
4. Virus such as chickenpox, mumps, rubella, HIV or Epstein-Barr
5. Being in contact with chemicals like pesticides and arsenic’
6. Autoimmune diseases like lupus where your own body attacks healthy cells mistakenly
7. Allopathic medicines such as antibiotics used to prevent blood clots and antiseizure drugs
8. Rare diseases that make blood clots in the body such as thrombotic thrombocytopenic purpura and disseminated intravascular coagulation
9. Viruses like mononucleosis (mono) or cytomegalovirus
10. Platelets might also get trapped in the spleen causing a low count. A woman may also experience low platelet count during pregnancy because the body gets rid of platelets more quickly
Do’s
- Consume fruits and green leafy vegetables daily
- Prefer any herbal preparation to maintain normal platelets count including papaya leaf and giloy
- Keep your body hydrated
Don’ts
- Try to avoid getting injured specially through any kind of cuts
- Avoid alcohol and processed foods
- Don’t treat or diagnose your own
- Avoid alcohol as it thins the blood and can make bleeding worse
- Avoid blood thinning medications
- Don’t use a hard toothbrush to prevent bleeding gums